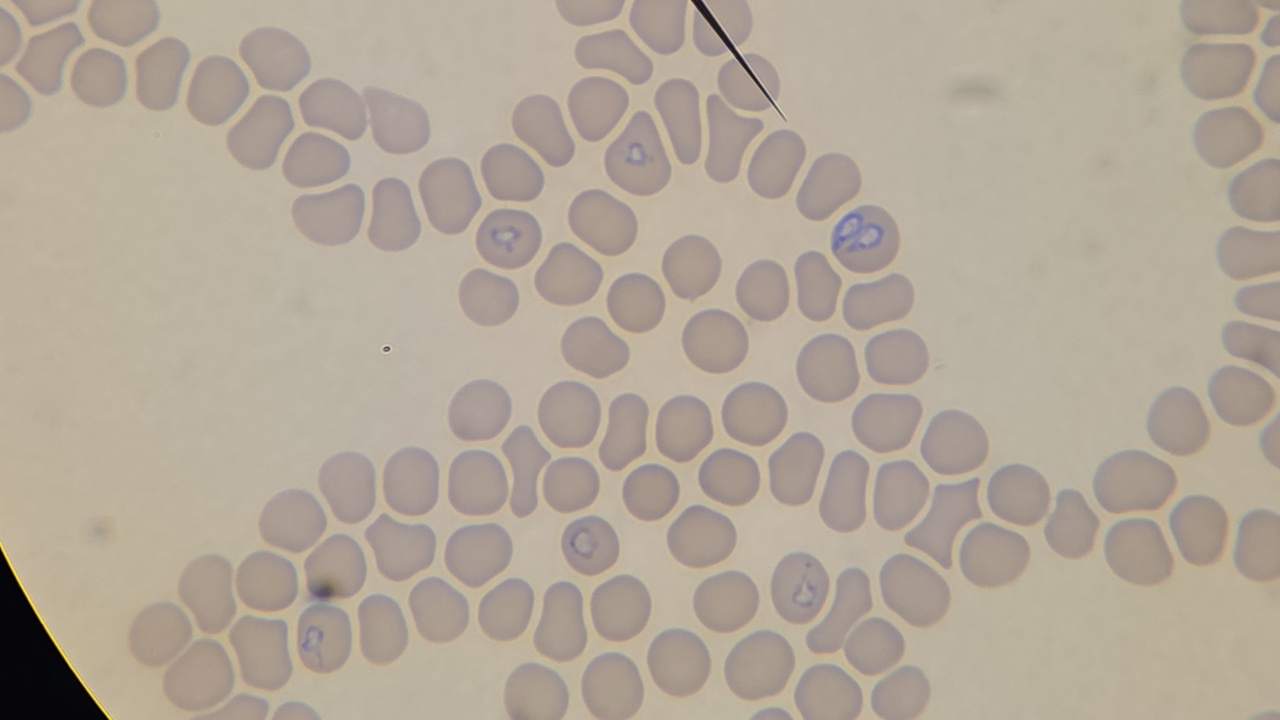
Babesia Canis - choroba odkleszczowa

Opis działalności firmy Tomasz Smołka, lek. wet., Przychodnia weterynaryjna św. Franciszka w Rudziczka
W Przychodni weterynaryjnej św. Franciszka pracujemy pod kierownictwem lekarza weterynarii Tomasza Smołki. Działamy dla Państwa od 2013 roku. Siedzibę mamy w miejscowości Rudziczka, na terenie województwa śląskiego.
Produkty i usługi
Zdrowie i dobre samopoczucie Twojego zwierzaka są dla nas priorytetem. Jako zespół doświadczonych weterynarzy oferujemy usługi weterynaryjne, dbając o zdrowie psów, kotów oraz innych zwierząt futerkowych. Dzięki nowoczesnemu sprzętowi diagnostycznemu oraz specjalistycznej wiedzy zapewniamy skuteczne leczenie i profilaktykę, aby Twój pupil cieszył się długim i szczęśliwym życiem.
W ramach opieki internistycznej diagnozujemy i leczymy różnego rodzaju schorzenia, a nasi specjaliści pomagają zarówno w przypadku nagłych problemów zdrowotnych, jak i długoterminowej terapii chorób przewlekłych. Nasza oferta to:
- stomatologia weterynaryjna,
- chirurgia weterynaryjna,
- okulistyka,
- kardiologia,
- badania krwi,
- badania moczu,
- badania RTG,
- badania USG.
Psi kardiolog przeprowadza szczegółowe badania serca, diagnozując i leczący choroby układu krążenia u psów i kotów. W przypadku problemów ze wzrokiem, nasz okulista dla zwierząt ocenia stan oczu i podejmuje odpowiednie działania, aby zapobiec dalszemu pogarszaniu się wzroku. Równie ważna jest profilaktyka i leczenie schorzeń jamy ustnej. Psi dentysta zajmuje się usuwaniem kamienia nazębnego, ekstrakcją chorych zębów oraz leczeniem stanów zapalnych w obrębie jamy ustnej.
Szczegółowe informacje znajdują się na naszej stronie internetowej.
Zasięg działania
Firma Tomasz Smołka, lek. wet., Przychodnia weterynaryjna św. Franciszka z lokalizacji: Rudziczka świadczy usługi m.in. w wymienionych obszarach:
śląskie, pszczyński